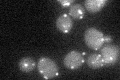
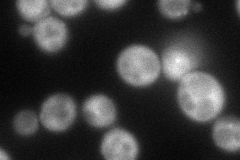
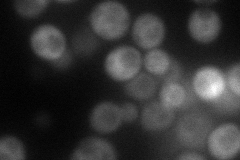
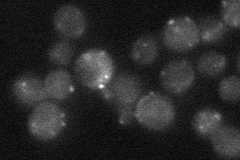
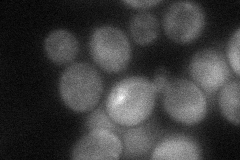
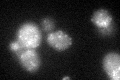
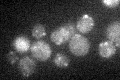

View description
AAA-peroxin that heterodimerizes with AAA-peroxin Pex6p and participates in the recycling of peroxisomal signal receptor Pex5p from the peroxisomal membrane to the cystosol; induced by oleic acid and upregulated during anaerobiosis
Localization:
Intensity:
Fold change:
Significance:
-
C’ GFP library in SD
punctate26.76 -
N' NOP1pr-GFP in SD
cytosol71.9263 -
N' TEF2pr-mCherry in SD
cytosol66.574 -
N' NATIVEpr-GFP in SD
punctate24.4151 -
N' TEF2pr-VC and Cyto-VN in SD
cytosol44.8997 -
C’ GFP library in SD+DTT
punctate27.271.01No -
C’ GFP library in SD+H2O2

punctate28.781.07No -
C’ GFP library in Starvation Media
punctate28.531.06No -
C’ GFP library on the background of Pup2-DaMP

N/A -
C’ GFP library on the background of CCT mutant

N/A0N/AYes
